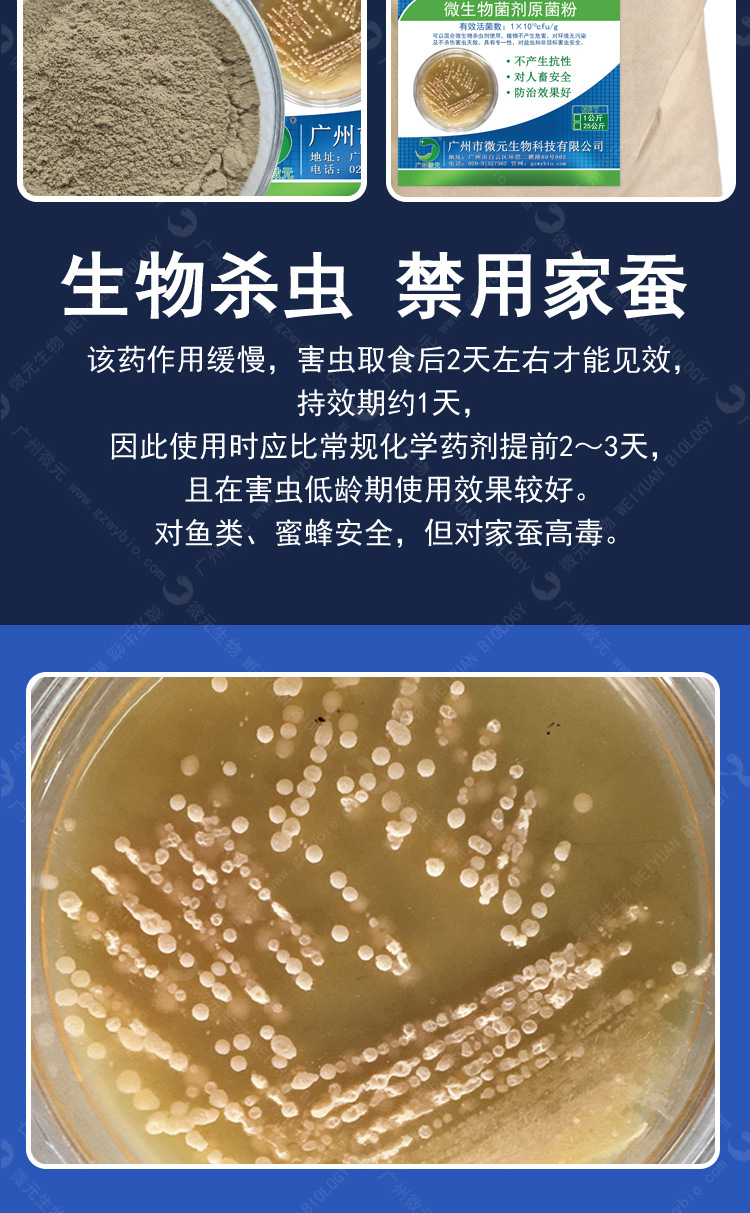
苏云金杆菌005.jpg

生物肥料 叶面肥 有机肥
普通会员
产品价格¥60.00元/千克
产品品牌未填
最小起订≥1 千克
供货总量30000 千克
发货期限自买家付款之日起 15 天内发货
浏览次数428
企业旺铺https://www.nmy188.com/index.php?homepage=13725293680a
更新日期2024-08-22 15:25
本网页所展示的有关【苏云金杆菌100亿/克 BT苏云菌杆菌生物杀虫剂 菜青虫粘虫小菜蛾_肥料_广州市微元生物科技有限公司】的信息/图片/参数等由农牧云的会员【广州市微元生物科技有限公司】提供,由农牧云会员【广州市微元生物科技有限公司】自行对信息/图片/参数等的真实性、准确性和合法性负责,本平台(本网站)仅提供展示服务,请谨慎交易,因交易而产生的法律关系及法律纠纷由您自行协商解决,本平台(本网站)对此不承担任何责任。您在本网页可以浏览【苏云金杆菌100亿/克 BT苏云菌杆菌生物杀虫剂 菜青虫粘虫小菜蛾_肥料_广州市微元生物科技有限公司】有关的信息/图片/价格等及提供【苏云金杆菌100亿/克 BT苏云菌杆菌生物杀虫剂 菜青虫粘虫小菜蛾_肥料_广州市微元生物科技有限公司】的商家公司简介、联系方式等信息。
在您的合法权益受到侵害时,欢迎您向1111@qq.com邮箱发送邮件,或者进入《网站意见反馈》了解投诉处理流程,我们将竭诚为您服务,感谢您对农牧云的关注与支持!
周一至周五
09:00 - 17:30




通过 